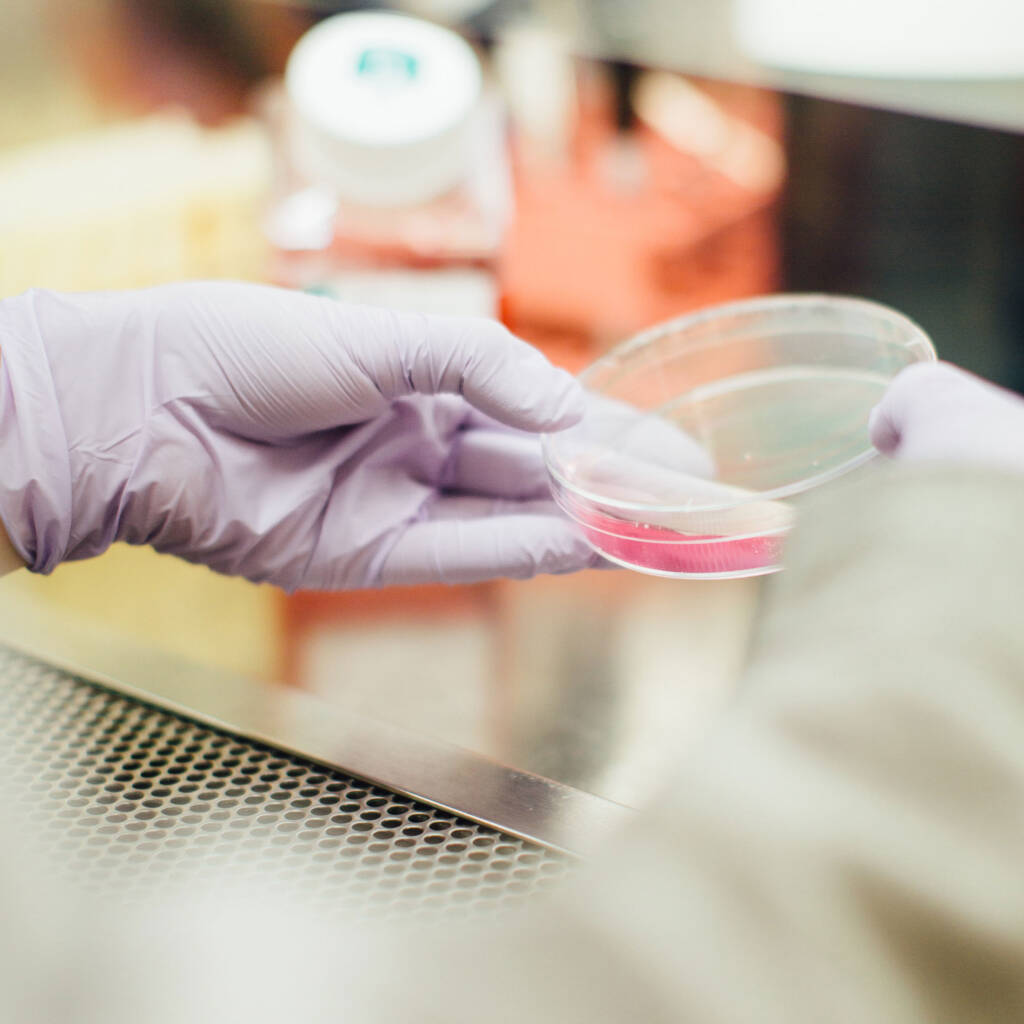
mbiomics laboratory

about us
Bringing together proprietary precision analytics and patient insights, we are building a pipeline of rationally selected microbial communities to achieve indication-specific treatment and address patient heterogeneity. Our goal is to access the gut microbiome's full immunological and metabolic potential to restore healthy microbial ecosystems and thereby overcome disease.
our approach
Recapitulating the clinical efficacy of fecal transplants by designing complex consortia with superior safety and disease-specific activity.

We established a proprietary fluorescence microscopy-based profiling technology (Woehrstein et al., Science Advances, 2017) with a combination of superior precision, sensitivity, taxonomic depth and quantification properties. With our multiplexing panels, we can rapidly and accurately decipher the in vivo microbiome composition of a human sample. These data are critical to better inform the selection of the optimal microbial strains for complex consortia with tailored disease-targeting properties and a superior efficacy and safety profile.
San Francisco, January 12-15, 2026
Brussels, February 03-05, 2026
Boston, February 10-12, 2026
Join us on our mission to develop superior microbiome-based therapeutics! Browse our current open positions or reach out directly via careers@mbiomics.com. We are excited to get in touch!
Open PositionsWe are constantly seeking strategic collaborations, clinical partnerships and outstanding scientific talent. If you are interested to work with us, to apply our mbiomics analytics technology, or if you have general questions about our microbiome-powered approach, don't hesitate to reach out to us.
Connect